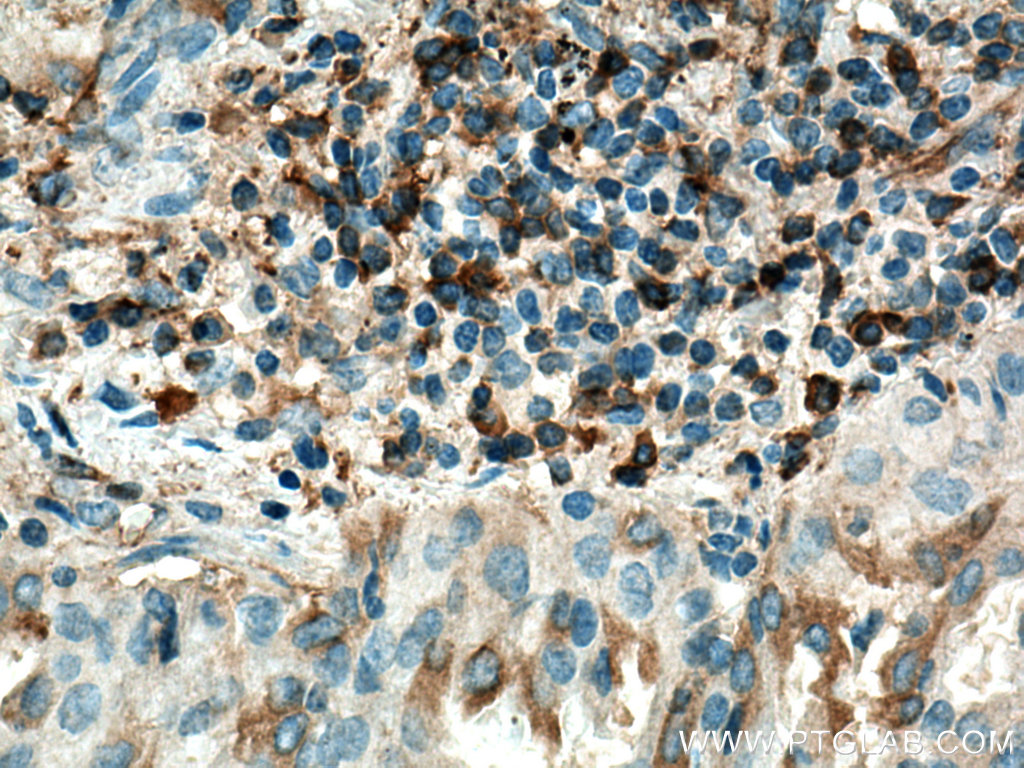

验证数据展示
经过测试的应用
| Positive WB detected in | mouse serum, human plasma, rat plasma |
| Positive IHC detected in | human liver cancer tissue, human lung cancer tissue Note: suggested antigen retrieval with TE buffer pH 9.0; (*) Alternatively, antigen retrieval may be performed with citrate buffer pH 6.0 |
推荐稀释比
| 应用 | 推荐稀释比 |
|---|---|
| Western Blot (WB) | WB : 1:2000-1:16000 |
| Immunohistochemistry (IHC) | IHC : 1:50-1:500 |
| It is recommended that this reagent should be titrated in each testing system to obtain optimal results. | |
| Sample-dependent, Check data in validation data gallery. | |
产品信息
16665-1-AP targets Haptoglobin in WB, IHC, IF, ELISA applications and shows reactivity with human, mouse, rat samples.
| 经测试应用 | WB, IHC, ELISA Application Description |
| 文献引用应用 | WB, IHC, IF |
| 经测试反应性 | human, mouse, rat |
| 文献引用反应性 | human, mouse |
| 免疫原 |
CatNo: Ag10143 Product name: Recombinant human HP protein Source: e coli.-derived, PGEX-4T Tag: GST Domain: 179-406 aa of BC058031 Sequence: MVSHHNLTTGATLINEQWLLTTAKNLFLNHSENATAKDIAPTLTLYVGKKQLVEIEKVVLHPNYSQVDIGLIKLKQKVSVNERVMPICLPSKDYAEVGRVGYVSGWGRNANFKFTDHLKYVMLPVADQDQCIRHYEGSTVPEKKTPKSPVGVQPILNEHTFCAGMSKYQEDTCYGDAGSAFAVHDLEEDTWYATGILSFDKSCAVAEYGVYVKVTSIQDWVQKTIAEN 种属同源性预测 |
| 宿主/亚型 | Rabbit / IgG |
| 抗体类别 | Polyclonal |
| 产品类型 | Antibody |
| 全称 | haptoglobin |
| 别名 | HP, BP, HAPT, HP2 ALPHA 2, HPA1S |
| 计算分子量 | 281aa,31 kDa; 228aa,25 kDa |
| 观测分子量 | 42 kDa |
| GenBank蛋白编号 | BC058031 |
| 基因名称 | HP |
| Gene ID (NCBI) | 3240 |
| RRID | AB_1939524 |
| 偶联类型 | Unconjugated |
| 形式 | Liquid |
| 纯化方式 | Antigen affinity purification |
| UNIPROT ID | P00738 |
| 储存缓冲液 | PBS with 0.02% sodium azide and 50% glycerol, pH 7.3. |
| 储存条件 | Store at -20°C. Stable for one year after shipment. Aliquoting is unnecessary for -20oC storage. |
背景介绍
HP(Haptoglobin) is also named as zonulin and belongs to the peptidase S1 family. HP, a plasma glycoprotein that binds free hemoglobin, has a tetrameric structure of 2 alpha(16 kDa and 9 kDa) and 2 beta(40 kDa) polypeptides that are covalently associated by disulfide bonds. In most species, apart from ruminants, Hp has a molecular mass of 100 kDa, consisting of two subunits of 40 kDa and two subunits of 9 kDa, although in a few species, such as man, genetic variant of Hp forms polymers of higher mass(PMID:2361363). Recent studies of haptoglobin show that certain oligosaccharide structures predominate in different diseases. For example, a highly-fucosylated structure is found in breast cancer and ovarian cancer, highly-sialylated structures in Crohn's disease and highly branched structures in alcoholic liver disease and fucosylated haptoglobin is a good serum marker for pancreatic cancer.(PMID:16385567).
实验方案
| Product Specific Protocols | |
|---|---|
| WB protocol for Haptoglobin antibody 16665-1-AP | Download protocol |
| IHC protocol for Haptoglobin antibody 16665-1-AP | Download protocol |
| Standard Protocols | |
|---|---|
| Click here to view our Standard Protocols |
发表文章
| Species | Application | Title |
|---|---|---|
Theranostics Interleukin-6 Induced "Acute" Phenotypic Microenvironment Promotes Th1 Anti-Tumor Immunity in Cryo-Thermal Therapy Revealed By Shotgun and Parallel Reaction Monitoring Proteomics. | ||
Clin Transl Med Single-cell transcriptomes reveal heterogeneity of high-grade serous ovarian carcinoma. | ||
Antioxid Redox Signal Control of Oxidative Stress and Inflammation in Sickle Cell Disease with the Nrf2 Activator Dimethyl Fumarate. | ||
World J Gastroenterol N-linked glycoproteomic profiling in esophageal squamous cell carcinoma | ||
Oncol Rep Proteomic-based analysis for identification of potential serum biomarkers in gallbladder cancer. |